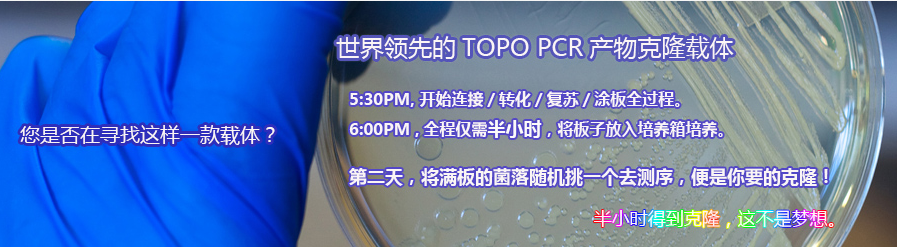
产品细节图片2

1. Qingkailing Injection Alleviates Experimental Autoimmune Uveitis in Rats via Inhibiting Th1 and Th17 Effector Cells. Biol. Pharm. Bull, 2012, 35(11) : 1991–1996
2. Expression Analysis of MAwuAG in Different Organs and Developmental Stages of Magnolia wufengensis. Chinese Bulletin of Botany, 2013, 48 (2): 1–1
3. Effect and Molecular Mechanism of DHA on Improving Rats Learning and Memory Ability, Food Science, 2012-11-9
4. Zinc Oxide Nanoparticles Induce Rat Retinal Ganglion Cell Damage Through Bcl-2,Caspase-9 and Caspase-12 Pathways Journal of Nanoscience and Nanotechnology. Vol. 13, 3769–3777, 2013
5. Zinc oxide nanoparticles decrease the expression and activity ofplasma membrane calcium ATPase, disrupt the intracellular calciumhomeostasis in rat retinal ganglion cells. The International Journal of Biochemistry & Cell Biology 45 (2013) 1849–1859
6. Zinc oxide nanoparticles inhibit Ca2+-ATPase expression in human lens epithelial cells under UVB irradiation. Toxicology in Vitro 27 (2013) 2117–2126
7. The organic extract from the Securidaca inhibits duck hepatitis B virus replication in vivo and hepatoprotective effect. Chin J Clinicians(Electronic Edition),December 1,2013,Vol.7,No.23
8. Disrupted calcium homeostasis is involved in elevated zinc ion-induced photoreceptor cell death. Archives of Biochemistry and Biophysics 2014, 560: 44–51
9. Molecular cloning and expression analysis of a myosin light chain 1 (MLC-1) gene from Indian meal moth Plodia interpunctella (Lepidoptera: Pyralidae). Entomological Research 2015, 45: 305-313
10.miR-143 inhibits tumor progression by targeting FAM83F in esophageal squamous cell carcinomaTumor Biol. 2016, DOI 10.1007/s13277-015-4760-9
11.An adenine nucleotide translocase (ANT) gene from Apostichopus japonicus; molecular cloning and expression analysis in response to lipopolysaccharide (LPS) challenge and thermal stress. Fish & Shellfish Immunology 2016, 49: 16 - 23
12.The Y137H mutation of VvCYP51 gene confers the reduced sensitivity to tebuconazole in Villosiclava virens. Scientific Reports 2015, 5:17575 | DOI: 10.1038/srep17575
13.Effects of the ninein like protein centrosomal protein on breast cancer cell invasion and migration. MOLECULAR MEDICINE REPORTS 2015, 12: 1659-1664
14.Molecular characterization of a 14-3-3 zeta gene from Plodia interpunctella: A potential marker for phylogenetic inference. Biochemical Systematics and Ecology 2015, 60: 171-176
15.MicroRNA-373 promotes migration and invasion in human esophageal squamous cell carcinoma by inhibiting TIMP3 expression. Am J Cancer Res 2016, 6(1):1-14
16.Development and Application of a Quantitative RT-PCR Approach for Quantification of Grapevine fanleaf virus. Acta Horticulturae Sinica 2016, 43 (3): 538-548.
17.Improved ganoderic acids production in Ganoderma lucidum by wood decaying components. Scientific Reports 2017, 7:46623 | DOI: 10.1038/srep46623
18.Identification of differentially expressed genes in the spleens of polyriboinosinic polyribocytidylic acid (poly I:C)-stimulated yellow catfish Pelteobagrus fulvidraco. Fish & Shellfish Immunology 2016, 56: 278-285.
19.Molecular cloning and expression analysis of the highly conserved eukaryotic translation initiation factor 5A (eIF‐5A) from Antheraea pernyi. Entomological research 2018, 48(1): 11-17.
20.A small heat shock protein 21 (sHSP21) mediates immune responses in Chinese oak silkworm Antheraea pernyi. International Journal of Biological Macromolecules 2018, 111: 1027-1031.
21.The Research on the Relationship of RAGE, LRP-1, and Aβ Accumulation in the Hippocampus, Prefrontal Lobe, and Amygdala of STZ-Induced Diabetic Rats. Journal of Molecular Neuroscience 2017, 62(1): 1–10.
22.Relationships of BRAF mutation and HMGB1 to papillary thyroid carcinoma. Biochemical and Biophysical Research Communications 2017, 486(4): 898-903.
23.nTranscriptome analysis of yellow catfish (Pelteobagrus fulvidraco) liver challenged with polyriboinosinic polyribocytidylic acid (poly I:C). Fish & Shellfish Immunology 2017, 68: 395-403.
24.Overexpression of lncRNA DANCR positively affects progression of glioma svia activating Wnt/β-catenin signaling. Biomedicine & Pharmacotherapy 2018, 102: 602-607.
25.Biochemical and genetic toxicity of dinotefuran on earthworms (Eisenia fetida). Chemosphere 2017, 176: 156-164.
26.Oxidative stress and gene expression of earthworm (Eisenia fetida) to clothianidin Ecotoxicology and Environmental Safety 2017, 142: 489-496.
27.De novo transcriptome assembly and analysis of differential gene expression following lipopolysaccharide challenge in Pelteobagrus fulvidraco. Fish & Shellfish Immunology 2018, 73: 84-91.
28.Autophagy-lysosome dysfunction is involved in Aβ deposition in STZ-induced diabetic rats. Behavioural Brain Research 2017, 320: 484-493.
29.Molecular identification and expression analysis of a goose-type lysozyme (LysG) gene in yellow catfish Pelteobagrus fulvidraco. Fish & Shellfish Immunology 2016, 58: 423-428.
30.A study of the damage of the intestinal mucosa barrier structure and function of Ctenopharyngodon idella with Aeromonas hydrophila. Fish Physiology and Biochemistry 2017, 43(5): 1223–1235.
31.Immunomodulatory effects of Longdan Xiegan Tang on CD4+/CD8+ T cells and associated inflammatory cytokines in rats with experimental autoimmune uveitis. Molecular Medicine Reports 2016, : 2746-2754.
32.De novo transcriptome assembly and analysis of differential gene expression following peptidoglycan (PGN) challenge in Antheraea pernyi. International Journal of Biological Macromolecules 2018, 112: 1199-1207.
33.Zinc ions regulate opening of tight junction favouring efflux of macromolecules via the GSK3β/snail-mediated pathway. Metallomics 2018, 10: 169-179.
34.Myeloid leukemia factor functions in anti-WSSV immune reaction of kuruma shrimp, Marsupenaeus japonicus. Fish & Shellfish Immunology 2017, 70: 416-425.
35.Gene microarray analysis of lncRNA and mRNA expression profiles in patients with high grade ovarian serous cancer. International Journal of Molecular Medicine 2018: 91-104.
36.Assessing the influence of 1-dodecyl-3-methylimidazolium chloride on soil characteristics and Vicia faba seedlings. Ecotoxicology and Environmental Safety 2018, 152: 114-120.
37.Linc-ROR induces epithelial-to-mesenchymal transition in ovarian cancer by increasing Wnt/β-catenin signaling. Oncotarget 2017, 8(41): 69983–69994.
38.Targeting the HMGA2 oncogene by miR-498 inhibits non-small cell lung cancer biological behaviors. European Review for Medical and Pharmacological Sciences 2018, 22: 1693-1699. |

文献和实验
文献和实验 技术资料
技术资料









